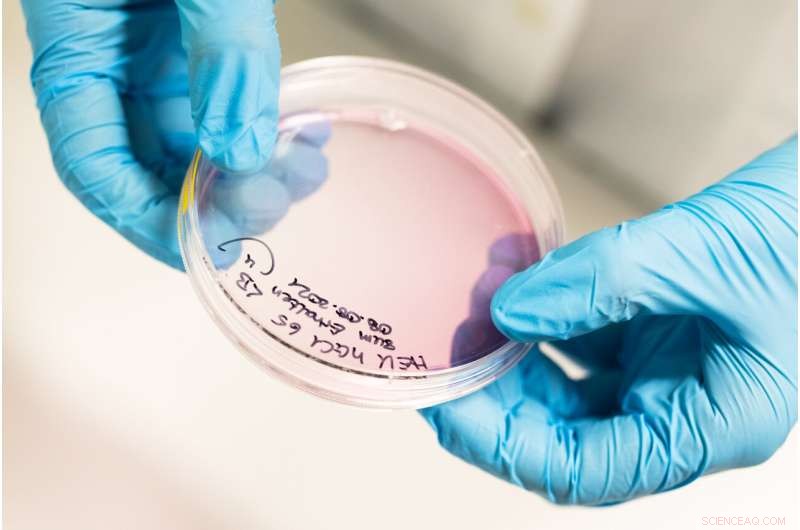
Unlocking the Sixth Sense: How Animals Use Earth’s Magnetic Field to Navigate

Doctoral student Vaishnavi Balaji uses a high-resolution confocal microscope to study how neurons inside the retina are interconnected. Credit: University of Oldenburg
Many animals use the Earth's magnetic field for orientation. But exactly how they do this remains for the most part a mystery. At the University of Oldenburg, researchers from across disciplines are working together to solve the puzzle.
A unique spectacle awaits anyone who visits the German island of Heligoland in the spring or autumn: On some days, particularly after bad weather, thousands of migratory birds, including small songbirds such as robins, northern wheatears, chiffchaffs and song thrushes, stop to rest on this rocky archipelago in the middle of the North Sea. Some spend the summer in Scandinavia or Russia. A few northern wheatears even fly across the Atlantic to Canada in the warmer months to breed and raise their young.
In winter, the birds migrate to warmer climes in southern Europe or Africa. Professor Henrik Mouritsen, who heads the Neurosensory Science research group at the University of Oldenburg, points to a particularly surprising aspect of this phenomenon: "Most songbirds migrate at night. Young birds that have never flown this route before migrate alone, without their parents or siblings," he explains. Northern Wheatears—pretty little songbirds that weigh just 25 grams—cover distances of up to 15,000 kilometers a year. "Their navigation systems are incredibly precise. Experienced migratory birds can find their way back to the exact same burrow they used for breeding the year before after traveling thousands of kilometers," says the biologist. The big question for Mouritsen is how exactly they do this—with a brain that in most cases weighs less than a gram.
Mouritsen has been searching for answers for a long time and his research has made significant contributions to solving the mystery. Since 2019 efforts have intensified. The biologist is working with a large international team in the Collaborative Research Center (CRC), which is conducting in-depth research into the impressive orientation abilities of vertebrates. The focus is on migratory birds such as European robins and blackcaps, and their astonishing ability to use the Earth's magnetic field for orientation.
Researchers from a wide range of disciplines including neurobiology, quantum physics, biochemistry, computer modeling and behavioral biology have joined forces in the CRC to find out how this still poorly understood sensitivity to the planet's magnetic field works. Led by Mouritsen, the team is studying the phenomenon at all levels: analyzing migration routes, conducting behavioral experiments and trying to determine how sensory stimuli are processed in the birds' brains and via which cells signals get there. The researchers' mission has brought them right down to the molecular level, where they are investigating the magnetic properties of certain proteins both in the laboratory and using complex computer models.
A quantum effect that might affect biomolecules
The team is hot on the trail of a fascinating mechanism: in recent years, evidence has mounted that the magnetic sensor of migratory birds is located in their eyes. Their magnetic sense appears to be based on a complicated quantum physical process that takes place in certain retinal cells. Mouritsen admits that at first glance, it is hard to imagine that such a process could form the basis for the magnetic compass in birds. Indeed, it was long considered unlikely that the extremely weak effects of quantum physics could influence biomolecules. However, together with various colleagues, the biologist has recently presented several findings that support this theory.
The search for the actual magnetic sensor has already yielded a hot contender: cryptochrome 4, a protein found in the retinas of migratory birds such as European robins, appears to be sensitive to the field lines of the Earth's magnetic field, thus triggering a cascade of chemical signals that transmit the stimulus to the brain. "Cryptochromes are present in the cells of many animals and plants," explains Oldenburg biochemist Professor Karl-Wilhelm Koch, who heads a subproject of the CRC. These proteins, of which there are six different types, can be light-sensitive and, among other things, ensure the functioning of the internal clock. Each animal species has its own, slightly modified variants of these proteins.
Magnetic for a fraction of a second
Cryptochrome 4 has a property that is very rare among biomolecules: "When it meets blue light, so-called radical pairs form," explains Professor Ilia Solov'yov, head of the Quantum Biology and Computational Physics research group at the University of Oldenburg. Radicals are molecules with an unpaired electron. Blue light triggers two such radicals in cryptochrome to form one coherent quantum mechanical state. This state lasts only a few fractions of a second, but during that fleeting moment, the protein is sensitive to the relatively weak influence of the Earth's magnetic field. Its direction determines into which of two possible products the cryptochrome subsequently converts—at least this was the theory put forward by the German physicist Klaus Schulten in the year 2000.
Together with colleagues from Oxford University, an Oldenburg research group led by Mouritsen was recently able to demonstrate this complex process in the cryptochrome 4 protein of the eyes of European robins. The researchers presented their findings in the cover story of a June 2021 issue of the journal Nature. An initial breakthrough came when Jingjing Xu, a doctoral student in Mouritsen's research group, succeeded in producing large quantities of cryptochrome 4 in the laboratory for the first time using bacterial cell cultures. The partners in Oxford were then able to demonstrate the protein's pronounced sensitivity to magnetic fields using ultra-sensitive techniques including magnetic resonance measurements and innovative optical spectroscopy methods. "The authors have brought us ever abiding closer to solving this mystery of sensory biology," zoologist Professor Eric Warrant of Sweden's Lund University commented in Nature.
Using computers as a microscope
An important contribution to this success were also the model calculations of physicist Ilia Solov'yov, who specializes in using computers like a microscope to gain a better understanding of molecules. "We calculate the position and motion of all the atoms in a protein using the fundamental equations of nature such as Newton's equations of motion, the laws of thermodynamics and quantum physics," he explains. These modeling operations require enormous computational resources: to model cryptochrome 4 in a realistic cellular environment Solov'yov has to calculate the behavior of about 100,000 atoms in tiny increments of time. For just one microsecond—a millionth of a second—he needs two weeks of computing time on a powerful supercomputer.

The light-sensitive protein cryptochrome 4 (the yellow substance in the tube) is only stable for a short time. Credit: University of Oldenburg
But it's worth the effort: with his "computer microscope," Solov'yov can uncover things that remain hidden using other methods—such as how electrons jump from amino acid to amino acid within the cryptochrome, or how changing environmental conditions affect the process. "The beauty of computer simulations is that we have complete control of the system," he says. In the case of the European robins' cryptochrome, Solov'yov, together with Professors Peter Hore, Christiane Timmel, and Stuart Mackenzie from Oxford, was able to identify which building blocks are crucial for the molecule's magnetic properties, and to confirm this using the proteins made in Mouritsen's group.
Solov'yov is currently modeling the cryptochromes of other organisms such as zebra finches, chickens, blackcaps and fish in order to identify differences in the proteins' magnetic properties. In addition, the physicist aims to measure the life span of radical pairs in various cryptochromes—a crucial property for their suitability as magnetic sensors.
A successful search in gene libraries
While the secrets of this unique protein are gradually being revealed, biochemist Karl-Wilhelm Koch is investigating how the stimulus it provides is transmitted further inside the cells. "The perception of the magnetic field has to be translated into the language of the nervous system," he explains. Koch and his team have set out to find proteins that interact with cryptochrome. "We have identified six potential candidates in genomic libraries," he says. The team presented the results of their genetic screening in the journal Scientific Reports in 2020.
Koch and his team are currently studying two of these proteins in greater detail. One is a visual pigment that is sensitive to red light while the second belongs to an important class of proteins that transmit signals within cells. "We have already found evidence that these two proteins do in fact form a complex with cryptochrome 4 and we are now performing further measurements using special biosensors to better understand these interactions," Koch reports.
The researchers are still puzzling over the significance of these findings. The fact that cryptochrome interacts with a photoreceptor molecule could mean that a magnetic stimulus triggers the same signaling cascade as visual stimuli. The interaction with the second protein, on the other hand, could indicate that the magnetic sensor triggers its own, as yet unknown, signaling pathway. "These are open questions that we aim to clarify," says Koch.
Light-sensitive nerve cells as sensors for the Earth's magnetic field
A strong indication that these two proteins do indeed play a role in magnetic sensing is the fact that they are present in the same cells as cryptochrome 4. The research team hadn't specified this as a prerequisite in its search for potential interaction partners. But it emerged that all three proteins are produced in the double cones—a specific type of sensory cells located in the retina. These light-sensitive nerve cells therefore appear to be the site of magnetic sensing.
"Double cones are photoreceptor cells found in fish, reptiles and birds," explains Oldenburg neurobiologist Professor Karin Dedek, who leads a subproject tasked with deciphering the nerve connections within the retina. These unusually shaped nerve cells consist of a larger principal member and smaller accessory member and make up about 30 to 40 percent of the photoreceptor cells in avian eyes. The CRC team thinks it likely that the cryptochrome molecules are not floating around freely in these cells but are in some way tethered. In the peripheral areas of the photoreceptors there are hundreds of parallel cell membranes. The scientists suspect that the proteins are fixed and aligned in rows here, which would increase their sensitivity to the direction of the magnetic field.
Dedek believes the peculiar geometry of the double cones makes them particularly suited to detecting the magnetic field: "For example, if the cryptochrome molecules in the two subunits are perpendicular to each other, that could aid the process of distinguishing between visual and magnetic stimuli." To understand how the retina encodes the stimuli, Dedek and her colleagues are studying the double cones and their interconnections with other neurons. "We want to know what types of cell then transmit the signal to the brain," she says. Another goal is to directly measure the reaction of the double cones to changes in the magnetic field—and thus provide direct evidence that these cells detect the magnetic field.
Various findings suggest that a region of the brain called Cluster N is responsible for processing the magnetic signals. It is located near the region that processes visual stimuli in avian brains and, as experiments by Mouritsen showed in 2005, is highly active in night-migratory songbirds in light conditions such as low-level star and moonlight. In an article that appeared in Nature in 2009, Mouritsen's research group was able to prove that Cluster N does indeed process magnetic compass stimuli by demonstrating that when this brain region is not functioning, birds can still use their star and sun compasses, but can no longer navigate using magnetic stimuli.
To find interaction partners, the researchers use the Two-Hybrid System, a technique involving petri dishes filled with a nutrient medium. Credit: University of Oldenburg
When electrosmog drives migratory birds off course
How exactly the birds perceive the Earth's magnetic field is unclear. "The most likely option is that birds see the magnetic field as a visual pattern," Mouritsen says. In laboratory studies, experiments have repeatedly shown that the geomagnetic field helps birds to find their way—and that disturbances can cause them to lose their orientation. But what happens when they are out in the wild is a different matter. Within the CRC, ornithologist Dr. Heiko Schmaljohann is addressing this specific question. "We are looking at whether the results of laboratory experiments are also relevant for free-flying birds," he says.
In recent years, Schmaljohann, who conducts research at the university as well as at the Institute of Avian Research in Wilhelmshaven, has been testing whether electrosmog disrupts orientation in European robins and northern wheatears after their stopover on Heligoland. He began the experiments after a group led by Mouritsen reported in Nature that electromagnetic interference generated by some electronic devices disrupted orientation in caged birds—a result that fits in well with the theory of the radical-pair mechanism. For Schmaljohann, these findings raised the question of whether electrosmog also affects free-flying birds in the wild, such as long-distance migrants, whose populations have long been in decline for reasons that remain unexplained.
Using the sun for orientation
To put this to the test, Schmaljohann and his team set up various radio receiving stations on the island and around the German Bight to track the departure direction of robins and northern wheatears when leaving Heligoland. The researchers then attached radio transmitters weighing 0.3 gram to some 140 northern wheatears and 140 robins and exposed the birds to low levels of electrosmog or no electrosmog at all for several hours. "We then released them and used the radio telemetry data to see how they behaved—whether electrosmog would perhaps prolong their stopover on Heligoland, or whether they would be disoriented when they started flying and head off in the wrong direction," says Schmaljohann. The team is currently in the process of publishing the results of the experiment, and the researcher would only reveal this much: "It appears that the birds use different sources of information to determine the migratory direction from Helgoland. It can be the stars, but also the magnetic field or landmarks."
There have been many indications over the years that the birds don't rely on only a single source of information on their long journey. In addition to stars and landmarks, it is likely that migratory birds use both the sun's trajectory and their sense of smell for orientation. And they probably have a second, even more mysterious magnetic sensor in their beaks, which possibly consists of tiny iron crystals and enables them to use the magnetic field like a map for navigation. This mechanism is being investigated in other subprojects within the Collaborative Research Center.
Together with Oldenburg computer modelers Professor Bernd Blasius and Dr. James McLaren, Schmaljohann is now investigating which of the various compasses plays the key role on different parts of the journey. "We are putting together individual pieces of information from numerous studies around the world, like a mosaic, to gain a better understanding of global migrations," says Schmaljohann. "After all, if we want to protect these animals on their long journeys, it is important to know what causes some migratory birds to change direction mid-journey and why they react differently to certain stimuli depending on their location."
"Birds definitely face major challenges when navigating across long distances," Mouritsen summarizes. Their amazing feats continue to offer many interesting challenges for the CRC team, too. The biologist is confident that more fascinating findings are yet to come: "We have achieved the easy part of our research objectives. Now things will get even more exciting."